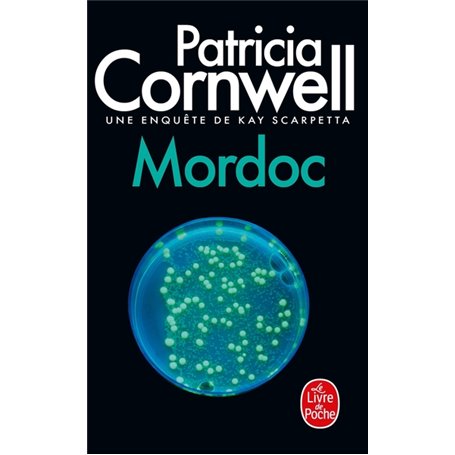
Mordoc

Mordoc
Format PocheAuteur : Patricia Cornwell

Livraison à la Réunion tout compris

Retours et SAV simplifiés

Ce produit dispose de la Garantie Isleden
Description
Des cadavres, Kay Scarpetta en a vu beaucoup dans sa carrière de médecin légiste. Souvent démembrés, découpés, étranglés&hellip Mais elle n'en avait pas encore vu dont la peau présente, comme signe distinctif, les symptômes de la même maladie. Une maladie depuis trente ans éradiquée de la planète !
Qui est donc Mordoc, tueur en série, assez audacieux pour se présenter à Kay sur l'Internet, assez diabolique et assez fou pour propager un virus mortel ?
Après Postmortem, Une mort sans nom et Morts en eaux troubles, la reine du thriller, au succès international, parvient à repousser un peu plus loin les limites de la terreur.
Caractéristiques
Caractéristiques
- Format
- Poche
- Auteur(s)
- Patricia Cornwell
- Collection
- Thrillers
- Date de parution
- 10/05/1999
Livraison à la Réunion
Notre priorité est votre satisfaction et nous mettons tout en œuvre pour vous apporter un service irréprochable.
Isleden livre chez vous à la Réunion !

Grâce à sa logistique ultra-performante, grâce à ses partenaires locaux, Isleden apporte votre commande directement chez vous ou dans votre boîte aux lettres si vous n'êtes pas là.
Si le colis est trop volumineux ou si sa valeur est importante, le colis sera remis au Bureau de poste le plus proche ou vous pourrez aller le chercher au moment qui vous arrange, en toute sécurité.
Commandez depuis votre canapé et faites vous livrer à domicile. C'est aussi simple que ça !
Livraison en moins de 15 jours sur plus d'1 million d'articles disponibles !

Chaque jour, Isleden ajoute à son catalogue de nouveaux fournisseurs et des milliers de produits. Revenez régulièrement pour trouver la perle rare.
Dès la commande passée, nous mettons tout en œuvre afin de réduire le temps de livraison. Nos transporteurs et partenaires locaux font le maximum pour vous apporter rapidement votre commande, dans les meilleures conditions.
Que vous commandiez un téléphone mobile, une perceuse ou un ordinateur portable, nous attachons une grande importance à ce que vous profitiez rapidement de votre achat.
Un service Exclusif pour les réunionnais !

Fini la galère des achats sur les sites qui ne livrent pas directement, rapatriés comme on peut, sans retour possible ni SAV, et parfois avec une ardoise à l'arrivée qu'on avait pas prévu.
Chez Isleden il n'y a pas de taxes ni de frais de douane. Nos prix sont tout compris et vous n'avez rien à payer à l'arrivée. Vous avez la possibilité de nous retourner votre produit sous 14 jours et le SAV est bien sûr pris en charge.
Tous nos produits sont garantis et bénéficient du service premium Isleden. en cas de panne, le formulaire disponible sur le site permet facilement d'enregistrer son SAV qui sera alors traité dans les meilleurs délais.